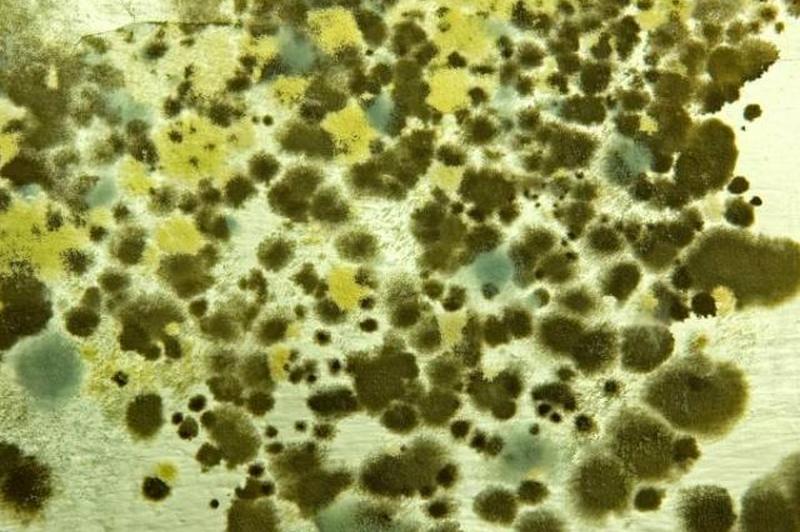

Плесень и грибок — это общие названия некоторых видов грибков . В целом профилактика и лечение проводятся так же, как и для других грибков.
Серая плесень
Это грибковое заболевание вызывает Botrytis cinerea. Это очень распространено и поражает многие виды растений. Симптомы различаются. В очень влажных условиях развивается гниль, покрывающаяся нечетким серым налетом, что и дало название болезни. Если влажность низкая, слой серой гнили может не развиться, даже если растение все равно гниет и сморщивается. На некоторых растениях, таких как помидоры или цветы цикламена, могут появиться небольшие обесцвеченные пятна.
Споры обычно заражают здоровые растения через раны. Они также могут напрямую атаковать деликатные ткани, такие как созревающие фрукты или цветы. Грибок может оставаться в спящем состоянии в развивающихся растениях, но позже вырывается наружу и вызывает гниль. У примулы грибок действительно может быть переносчиком в семенах. Ботритис также способен образовывать небольшие структуры, называемые склероциями, которые могут сохраняться в почве в течение многих месяцев.
Специального фунгицида для лечения серой гнили не существует. Хороший уход за садом — лучшая профилактика, а своевременное удаление поврежденного материала — лучший метод борьбы.
Закопченная плесень
Сапрофитные грибы вызывают черный налет, иногда встречающийся на деревьях и кустарниках. Многие садоводы находят это неприглядным, но это не болезнь и не наносит прямого вреда растению. Наличие сажистого плесени часто указывает на активность насекомых, которые могут нанести вред растениям.
Мучнистая роса
Ряд близкородственных видов грибов вызывает мучнистую росу. Каждый грибок имеет ограниченный круг хозяев, поэтому, хотя мучнистая роса может появиться на нескольких видах растений в саду, ее передача между видами маловероятна. Наиболее типичным признаком является сухая беловатая налет, покрывающий листья, кончики побегов, а иногда и цветки. У растения может быть замедленный или деформированный рост, а цветение может быть снижено. У некоторых растений листва обесцвечивается.
Хорошее движение воздуха является наиболее важным способом предотвращения мучнистой росы. Избегайте перенаселенности и обрезайте растения по мере необходимости. Поливайте сад утром, чтобы растения могли полностью высохнуть. По возможности выращивайте устойчивые сорта и сажайте их в оптимальных условиях выращивания. Немедленно удалите зараженный материал и уничтожьте его.
Фунгициды, доступные домашнему садоводу для борьбы с мучнистой росой, включают миклобутанил, пенконазол, флутриафол и смеси серы.
Ложная мучнистая роса
Ложная мучнистая роса вызывается несколькими видами грибков. Сначала он появляется в виде пятен или пятен на верхней поверхности листьев с пушистым наростом на нижней стороне листа непосредственно под пятном. Нарост часто имеет слегка фиолетовый цвет. Ложная мучнистая роса нуждается в теплой погоде и влажных условиях, чтобы процветать. При благоприятных условиях быстро распространяется.
Ложная мучнистая роса предотвращается теми же садоводческими методами, что и мучнистая роса. Для лечения можно использовать медные фунгициды.
Снежное разнообразие
Трава повреждена снежной плесенью, которая проявляется в виде коричневых пятен, за которыми следует пушистый белый рост грибов и других грибов. Они редко убивают траву, но могут вызывать неприглядные пятна. Хороший уход за газоном – лучший контроль.